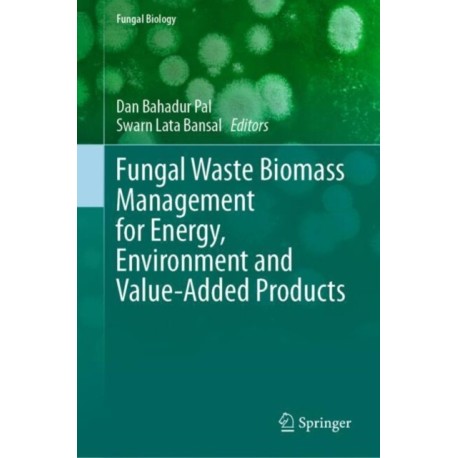

Kurv
Vare
varer
(tom)
Ingen varer
Fastlægges senere
Forsendelse
0,- kr
I alt
Fungal Waste Biomass Management for Energy, Environment and Value-Added Products
(Bog, Hardback, Engelsk)
Beskrivelse
Bioconversion of waste is a natural process aiding in the recovery of resources and biotechnology-facilitated natural recycling processes. Biotechnological treatments to food processing wastes found in large quantities can produce useful end products, such as microbial biomass protein, while wastes are also purified during the process.
Læsernes anmeldelser (0)
Alle detaljer
| Forlag | Springer International Publishing AG |
| Type | Bog |
| Format | Hardback |
| Sprog | Engelsk |
| Udgivelsesdato | 11-03-2025 |
| Første udgivelsesår | 2025 |
| Serie | Fungal Biology |
| Illustrationer | 27 Illustrations, color; 7 Illustrations, black and white |
| Fagredaktør | Dan Bahadur Pal, Swarn Lata Bansal |
| Originalsprog | Switzerland |
| Sideantal | 325 |
| Indbinding | Hardback |
| Forlag | Springer International Publishing AG |
| Sideoplysninger | 325 pages, 27 Illustrations, color; 7 Illustrations, black and white |
| Mål | 235 x 155 |
| ISBN-13 / EAN-13 | 9783031825989 |


